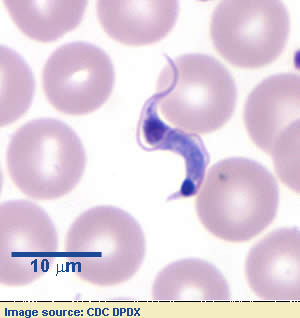

Eukaryotes
1/19
There's no tags or description
Looks like no tags are added yet.
Name | Mastery | Learn | Test | Matching | Spaced |
|---|
No study sessions yet.
20 Terms
antigenic variation and example
changing surface proteins to evade immune system
ex: giardia’s VSPs (variant-specific surface proteins)
apicomplexan life cycle (and example)
ex: Plasmodium - malaria
T. gandii and Cryptosporidium
S → M → T → M
1) Sporozoite infects
2) Merozoite forms and multiplies via binary fission in schizont
3) Trophozoite stage
4) Merozoite release again → some mature into macrogametocytes ♀ and microgametocytes ♂
dimorphism and example
fungi alter between yeast like unicellular organisms (higher temps) and temperature mycelial forms (lower temps)
Candida dublinienis
Saprolengia “fish fuzz”
→ sapro- loves water! spores shaped like pears (primary) and kidneys (secondary)
hyphae collection makes cotton tufts on infected fish
water mold that forms oomycetes and causes major aquaculture industry harm
malachite green used to treat, but has been banned

Giardia lamblia “beaver fever”
→ 2 nuclei, 4 flagella, no mitochondria = double trouble diarrhea
uses VSPs
diplomonad - 2 stages
1) trophozoite - motile, 2 nuclei + 4 flagella
2) cyst - 4 nuclei
T. cruzi “Chaga’s Disease”
→ chagas kisses your heart forever
one cell and one flagella
vector: kissing bug poops out trypomastigote after feeding
forms:
amastigote (intracellular, no flagella)
trypomastigote (flagella, motile, infective)
hides in heart and digestive muscles
more dehibilitating than malaria

Paragonimus westermani “Oriental Lung Fluke”
→ cercariae crustacean = crusty cough
eggs → miracidium → snail
cercariae → invade crustaceans → encyst as metacercariae
eating them = lung infection
mimics TB (peural effusion, blood stained septum, pneumonia, fibrous nodules)
Leishmania dovani
→ Leish loves macrophages, fever, and dark
female sandfly bites infect 1 million annually
2 forms: triggered by temp difference between fly and host
promastigote (flagellated, in fly)
amastigote (nonflagellated, in humans)
Kinetoplast (mitochondrial DNA) used to identify
replicates in macrophages
causes fever, organ swelling, darkened skin
Balamuthia mandrillaris “Brain Eating Amoeba”
→ brain eating amoeba = balamuthia = bad news/bad wounds
free living ameoba enters human through wounds/inhalation causes Granulomatous Amebic Encephalitis
2 forms use psuedopodia to move
1) trophozoite (infective)
2) cyst (dormant)
90% fatality
Plasmodium falciparum “Malaria”
→ falciparum = fever from female anopheles
infects 250 M a year through Anopheles mosquito
most virulent Apicomplexan
causes multiorgan failure
release/rerelease of merozoites causes fever/chills
new R21 vaccine 70% effective
Piscinoodinium pillulare (Velvet/Gold Dust Disease)
dioflagellate algae in freshwater
mixotrophic (photosynthetic and parasitic)
attatches to fish w/ rhizoids
3 life stages:
tomont (encysted, reproductive)
dinospore (free-swimming infective)
trophont (feeding)
secretes proteases/lipases that cause necrosis
Ascaris lumbricoides “Nematode roundworm”
900M cases annually, 10K deaths
Neglected Tropical disease
Male: small curved tail
Female: long straight tail
uses Ascaris Trypsin Inhibitor (ATI) to inhibit host digestive system
follows Hepato-Tracheal-Migration
Enterobius vermicularis “Pinworm”
→ pin scotch tape to itchy butt
females lay eggs in jelly like substance around anus
females are longer w/ pin shaped tail
causes perianal pruritus (anal itching)
self infection through scratching
Diphyllobothrium latum “Fish Tapeworm”
recall tapeworm anatomy
eggs hatch in cold water → coracidia → ingested by crustaceans
larvae hatch in crustaceans → humans pick up uncooked
freeze at -18C for 24 hrs to kill
causes gastrointestinal pain, vomiting, diarrhea
Naegleria fowleri “Brain-eating Amoeba”
causes Primary Amoebi meningoencephalitis
freshwater
3 stages:
trophozoite (feeding/reproductive)
flagellate (motile)
cyst
humans accidental hosts
attaches to nasal epitheliam via Nfa1
destroys tissue with trogocytosis, proteases, and phospholipases
Schistosoma mansoni “Blood fluke”
flatworm (Platyhelminth)
causes intestinal/hepatosplenic schistosomiasis
200M people annually affected
eggs→ miricidia → infect snails → sporocysts → cercariae → infect humans (liver)
eggs trigger immune response
candida dubliniensis
dimorphic fungi → mycelial and unicellular forms
in mouth and GI as normal flora
forms chlamydospores to survive harsh conditions
filamentous hyphae form is most invasive
antibiotic can allow growth
Taenia solium “Pig tapeworm”
platyhelminth
causes taeniasis and cysticerosis (larvae migrate to brain tissue)
4 suckers and double row of hooklets
Pfiesteria piscicida “non-photosynthetic Dinoflagellate algae”
East coast issue — 1 B fish killed in 1991
2 flagella
2 forms:
motile — naked cell w/out cellulose plates
cyst
attaches to wounded fish and secretes neurotoxins
Rhizocephalans “Parasitic barnacle”
crustacean host (unsclerotizes cuticles)
grows root system in host from vermigon which is injected into host
males enter crustation by a separate system
causes shrinking of sexual organs